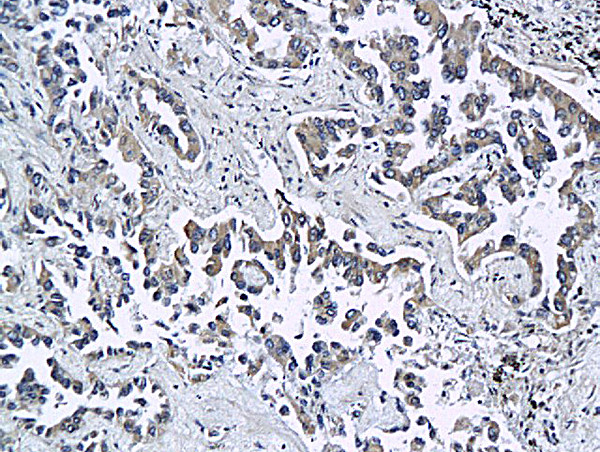
ESAM Antibody in Immunohistochemistry (Paraffin) (IHC (P))

Search
Bioss
ESAM Polyclonal Antibody
{{$productOrderCtrl.translations['antibody.pdp.commerceCard.promotion.promotions']}}
{{$productOrderCtrl.translations['antibody.pdp.commerceCard.promotion.viewpromo']}}
{{$productOrderCtrl.translations['antibody.pdp.commerceCard.promotion.promocode']}}: {{promo.promoCode}} {{promo.promoTitle}} {{promo.promoDescription}}. {{$productOrderCtrl.translations['antibody.pdp.commerceCard.promotion.learnmore']}}
产品信息
BS-5838R
种属反应
宿主/亚型
分类
类型
抗原
偶联物
形式
浓度
规格
纯化类型
保存液
内含物
保存条件
运输条件
靶标信息
ESAM is a 55-kDa membrane protein composed of 2 extracellular Ig domains, a single transmembrane domain, and a 120 amino acid cytoplasmic domain. ESAM is related to members of the junctional adhesion molecule (JAM) family, and is expressed on endothelial cells and activated platelets. ESAM at endothelial tight junctions plays a role in the regulation of vascular permeability, in response to agents such as VEGF or extravasating neutrophils.
仅用于科研。不用于诊断过程。未经明确授权不得转售。
篇参考文献 (0)
生物信息学
蛋白别名: 2310008D05Rik; Endothelial cell-selective adhesion molecule; HUEL (C4orf1)-interacting protein; LP4791 protein; unnamed protein product
基因别名: 2310008D05Rik; ESAM; Esam1; NEDIHSS; UNQ220/PRO246; W117m
UniProt ID: (Human) Q96AP7, (Rat) Q6AYD4, (Mouse) Q925F2
Entrez Gene ID: (Human) 90952, (Rat) 300519, (Mouse) 69524